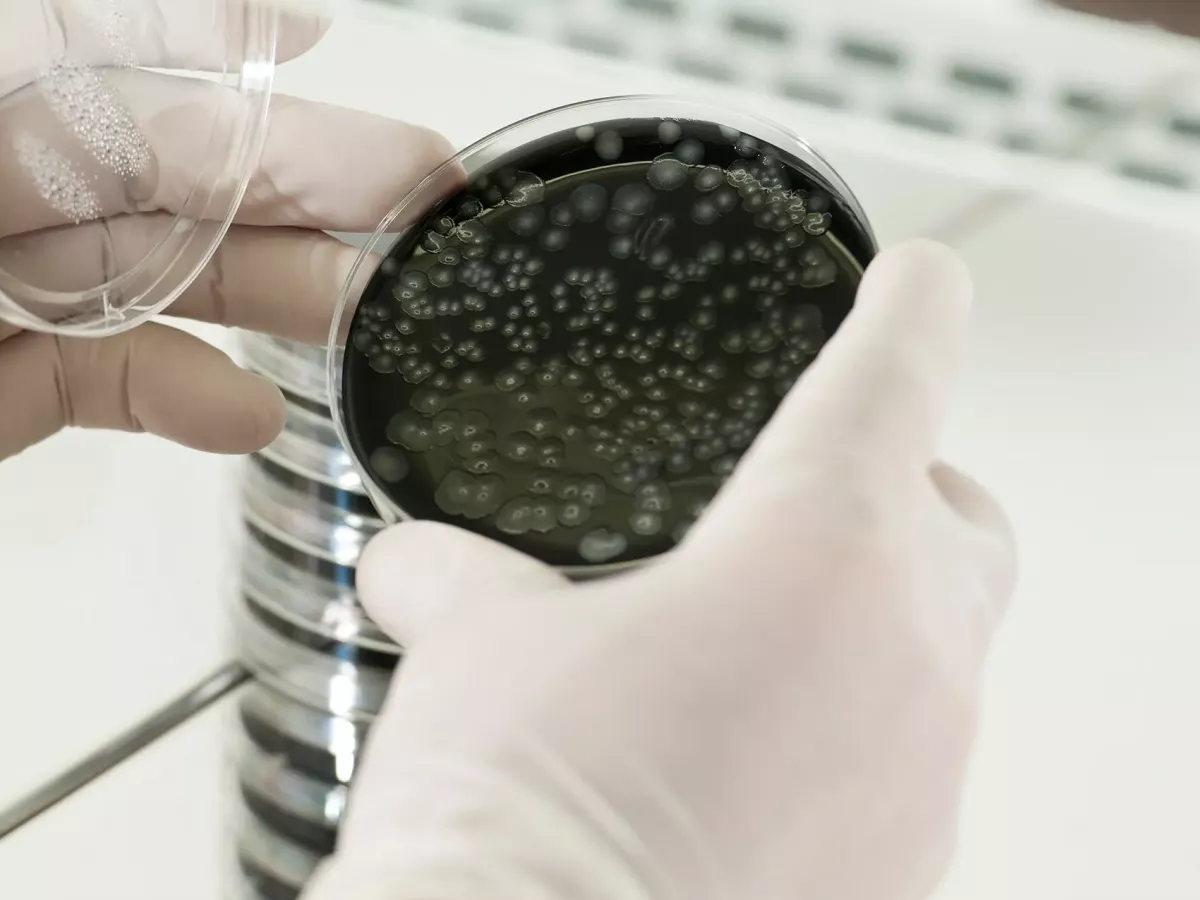

-
 Ihr Ansprechpartner für
Ihr Ansprechpartner fürLaborarbeiten
Zertifiziertes Labor
Wir arbeiten generell mit einem externen, zertifizierten und akkreditierten Labor zusammen.
Alle Mitarbeiter, die die Proben entnehmen sind geschult nach VDI 6022 und 6023.
Die Ergebnisse werden am gleichen Tage der Probeentnahme noch, von vor Ort, zum Labor versandt.
Übersichtliche Laborergebnisse und Handlungsempfehlungen sind selbstverständlich.
Bei Grenzwertüberschreitungen werden Sie zusätzlich von Ihrem Kundenbetreuer sofort angerufen, noch bevor Sie die Unterlagen per Mail vorliegen haben.

-
 Ihr Ansprechpartner für
Ihr Ansprechpartner fürLaborarbeiten
Alle Mitarbeiter, die die Proben entnehmen sind geschult nach VDI 6022 und 6023.
Die Ergebnisse werden am gleichen Tage der Probeentnahme noch, von vor Ort, zum Labor versandt.
Übersichtliche Laborergebnisse und Handlungsempfehlungen sind selbstverständlich.
Bei Grenzwertüberschreitungen werden Sie zusätzlich von Ihrem Kundenbetreuer sofort angerufen, noch bevor Sie die Unterlagen per Mail vorliegen haben.

Oberflächentests
Oberflächentests

TRINKWASSERUNTERSUCHUNG FÜR SAUBERES TRINKWASSER
Für alle Großanlagen ( mind.3 Ltr.Leitungsinhalt oder ein Boiler >300 Ltr.Inhalt ) sind wiederkehrende Trinkwasserprobennahmen gesetzlich vorgeschrieben.
Wir führen diese Trinkwasserprobe für Sie durch und erinnern daran, wenn die wiederkehrenden Trinkwasseruntersuchungen wieder anstehen.
Eine Begutachtung des gesamten Systems ist damit zwingend erforderlich und eingeschlossen. Hinweise werden mit Ihnen direkt besprochen und abgestellt.
Der Kunde stellt nur die erforderlichen Probenahmenstellen, die vorher besprochen wurden, durch seinen Fachhandwerker sicher.
Diese Kosten sind voll umlagefähig, da sie dem „Stand der Technik “entsprechen und von Ihnen erwartet werden.
Ein aussagefähiges Zertifikat zum Dokumentation und zum Aushang kann Ihren Mietern / Nutzern erstellt werden.
Rohrleitungsspülung zur Legionella Profilaxe/ Bekämpfung
Biofilme, der Nährboden für die Legionella, ist in vielen wasserführenden Leitungen zu finden.
Legionellen werden ständig, auch neue, vom Wasserversorger mit geliefert. Eine Grenzwertüberschreitung kann, bei Stagnation oder nicht richtiger Wartung der Anlagen, schnell eintreten.
Wir helfen Ihnen dabei- ihre System „SAUBER“ zu halten.
Bei einem Problem, können Leitungssysteme gespült und behandelt werden. Dies ist häufig die Grundlage für eine ordentliche Wasserbereitstellung der Zukunft.